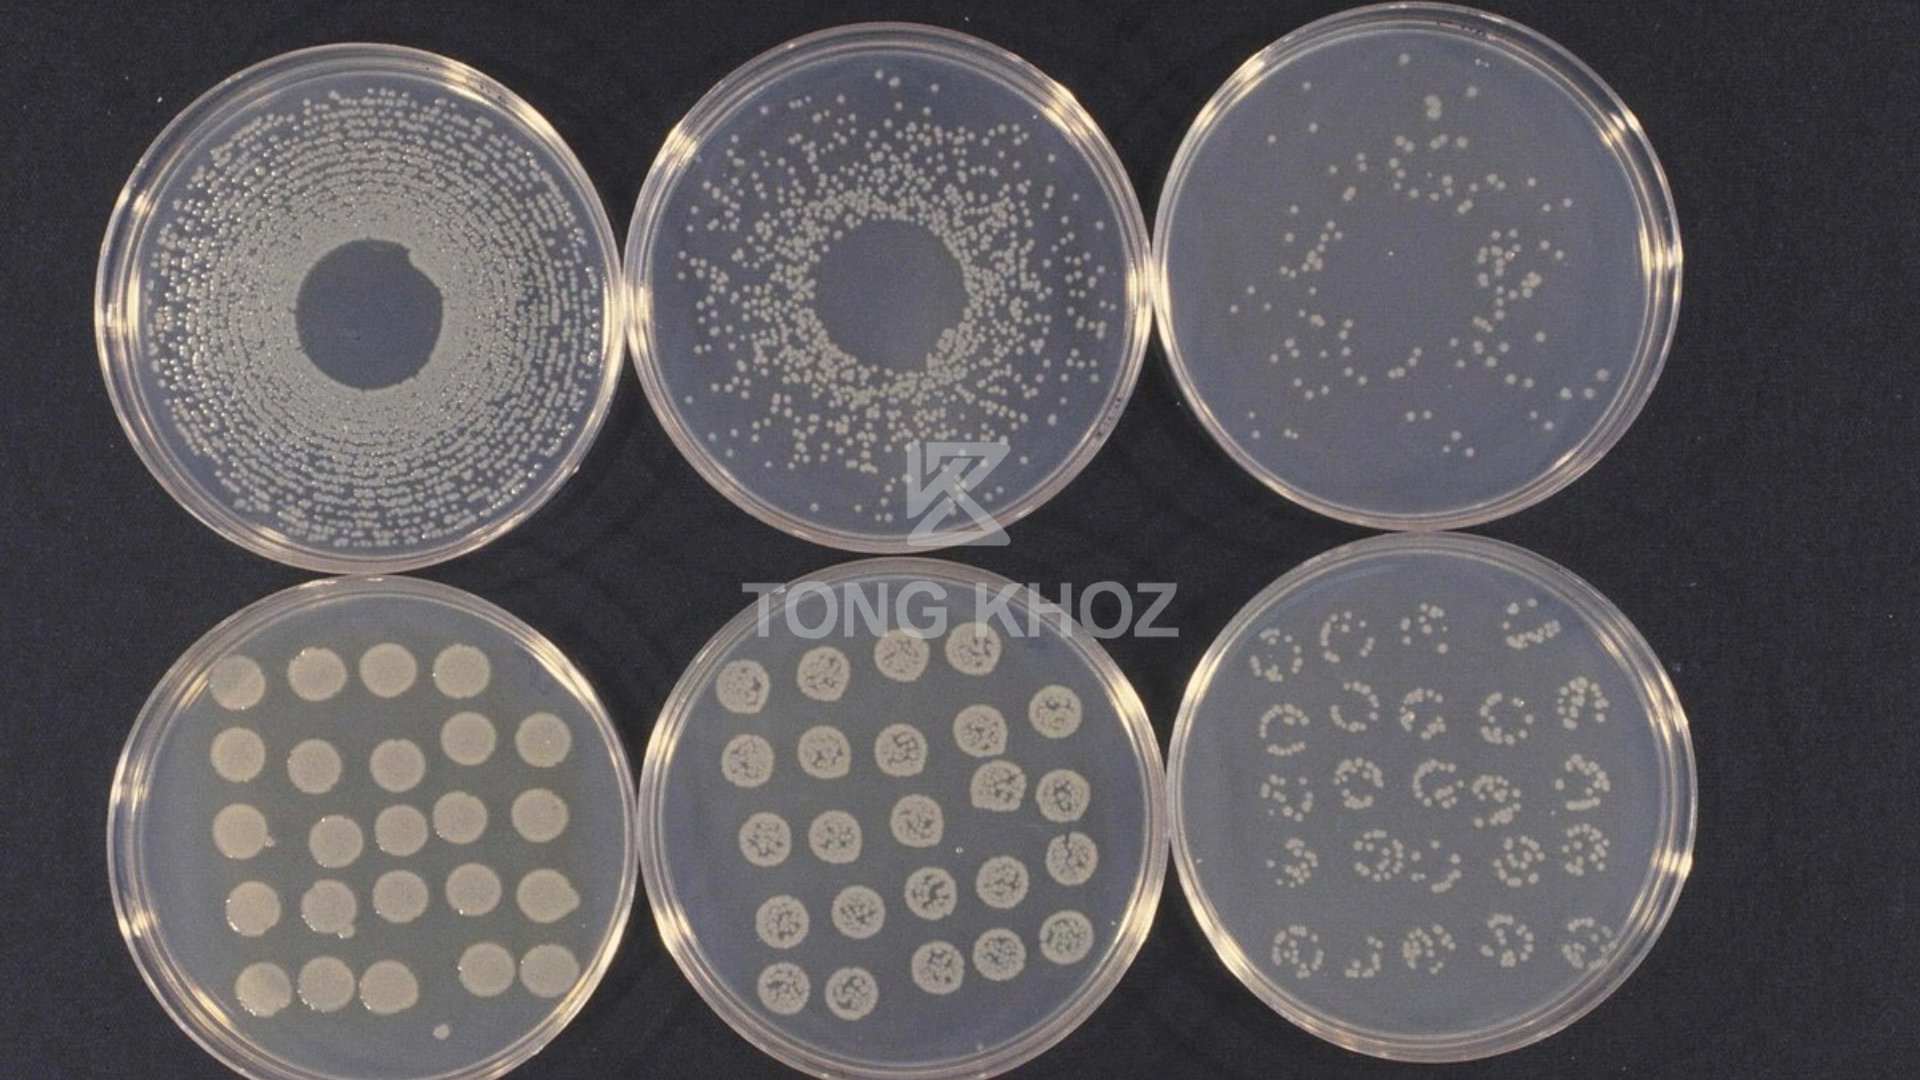

Bệnh đốm lá bí đao là một trong những bệnh phổ biến, thường xuất hiện vào mùa mưa hoặc thời tiết ẩm thấp. Bệnh gây ra các vết đốm vàng, nâu hoặc đen trên lá, khiến cây suy yếu và giảm năng suất nghiêm trọng. Nguyên nhân chủ yếu do nấm Cercospora và Alternaria phát triển mạnh trong điều kiện ẩm ướt, vườn trồng dày hoặc thoát nước kém. Bài viết này, Tổng Kho Z sẽ hướng dẫn bà con cách nhận biết và phòng trị bệnh đốm lá trên bí đao hiệu quả, giúp vườn luôn xanh khỏe, năng suất ổn định quanh năm.
1. Nguyên nhân gây bệnh đốm lá bí đao
Tác nhân chính
- Bệnh đốm lá do vi khuẩn Pseudomonas syringae pv. lachrymans gây ra – một loại vi khuẩn phổ biến trên cây bí đao ở nhiều vùng trồng.
- Vi khuẩn tấn công trực tiếp vào mô lá, làm giảm khả năng quang hợp và khiến cây suy yếu nhanh.
- Chúng tồn tại lâu trong đất, tàn dư cây trồng, hạt giống hoặc dụng cụ canh tác chưa được khử trùng.
- Khi gặp điều kiện thuận lợi, vi khuẩn xâm nhập qua vết thương nhỏ trên lá và lây lan nhanh trong vườn.
Điều kiện phát sinh và phát triển
- Bệnh phát triển mạnh khi nhiệt độ từ 20–25°C, độ ẩm không khí trên 80%.
- Thời tiết mưa nhiều, ẩm ướt kéo dài tạo điều kiện cho vi khuẩn sinh sôi nhanh.
- Đất trồng kém thoát nước hoặc bị ngập úng càng tăng nguy cơ bùng phát bệnh đốm lá.
- Vườn trồng rậm rạp, thiếu thông thoáng cũng là môi trường thuận lợi cho vi khuẩn lan truyền.
2. Biểu hiện bệnh đốm lá bí đao
Thời điểm xuất hiện
- Bệnh đốm lá thường xuất hiện vào mùa mưa, đặc biệt giai đoạn ra hoa đến khi nuôi trái.
- Độ ẩm cao, lá ướt thường xuyên khiến nấm và vi khuẩn phát triển mạnh, lan nhanh trên toàn vườn.
Trên lá
- Ban đầu, trên bề mặt lá xuất hiện các đốm nhỏ màu vàng nâu hoặc nâu xám.
- Viền ngoài của vết bệnh có màu vàng nhạt, hình dạng không cố định.
- Khi bệnh nặng, vết đốm lan rộng, lõm giữa và chuyển sang màu xám, làm lá khô giòn và dễ rụng.
- Một số lá bị bệnh nặng xuất hiện lỗ thủng, xơ xác, mất khả năng quang hợp.
Ảnh hưởng chung
- Bệnh làm giảm diện tích lá khỏe, khiến cây bí đao suy yếu, sinh trưởng chậm.
- Nếu không xử lý sớm, lá rụng nhiều, toàn cây sẽ mất sức, ảnh hưởng đến năng suất và chất lượng trái.
3. Hậu quả của bệnh đốm lá bí đao
Ảnh hưởng đến sinh trưởng của cây
- Bệnh làm lá hư hỏng, giảm khả năng quang hợp, khiến cây thiếu dinh dưỡng nghiêm trọng.
- Cây bí đao suy yếu, còi cọc, chậm phát triển, không đủ sức nuôi hoa và trái.
- Khi bệnh nặng, lá khô giòn và rụng sớm, làm cây mất sức hoàn toàn.
- Trái nhỏ, phát triển kém, màu sắc xấu và dễ bị thối trong quá trình thu hoạch.
Ảnh hưởng đến năng suất và kinh tế
- Bệnh đốm lá có thể làm giảm năng suất 40–70%, đặc biệt ở những ruộng không xử lý sớm.
- Trái bị bệnh méo mó, kém chất lượng, khó tiêu thụ, ảnh hưởng trực tiếp đến thu nhập người trồng.
- Khi bệnh lan rộng, bà con buộc phải nhổ bỏ cây và trồng lại, gây tốn kém chi phí đầu tư.
- Thiệt hại kéo dài khiến hiệu quả kinh tế giảm và ảnh hưởng đến sinh kế lâu dài.

4. Biện pháp phòng và trị bệnh đốm lá bí đao
4.1. Biện pháp canh tác
- Luân canh với cây trồng khác họ bầu bí để cắt nguồn bệnh trong đất.
- Không trồng bí đao liên tục nhiều vụ tại cùng một khu vực.
- Làm đất tơi xốp, thoát nước tốt, tránh úng cục bộ trong mùa mưa.
- Dọn sạch tàn dư cây bệnh, cỏ dại, hạn chế nơi trú ngụ của nấm và vi khuẩn.
- Giữ mật độ trồng hợp lý, giúp vườn thông thoáng, lá khô nhanh sau mưa.
4.2. Biện pháp dinh dưỡng
- Bón phân cân đối, tránh thừa đạm, thiếu kali và vi lượng.
- Tăng cường phân hữu cơ vi sinh để cải tạo đất, giảm mầm bệnh.
- Sử dụng định kỳ VITAMIN-Z để giúp cây khỏe mạnh, lá dày và xanh bền.
- Kết hợp CASIBO-Z hoặc XTRA FRUIT để phục hồi cây, tăng sức đề kháng với nấm khuẩn.
- Bổ sung Bo, Kẽm, Magie giúp cây phát triển cân đối và ít bị đốm lá hơn.
4.3. Biện pháp hóa học (khi bệnh xuất hiện)
- Phun sớm các hoạt chất trừ nấm, vi khuẩn như: Mancozeb, Chlorothalonil, Copper Oxychloride, Difenoconazole, Propineb, Azoxystrobin,..
- Luân phiên hoạt chất sau mỗi 7–10 ngày để tránh hiện tượng kháng thuốc.
- Phun đều 2 mặt lá vào sáng sớm hoặc chiều mát, tránh trời nắng gắt.Khi bệnh nặng, kết hợp Validamycin hoặc Kasugamycin để tăng hiệu quả kháng khuẩn.
4.4. Biện pháp sinh học
- Dùng nấm đối kháng Trichoderma trộn vào đất trước khi trồng.
- Ủ phân chuồng kỹ với chế phẩm sinh học để giảm mầm bệnh tồn lưu.
- Phun chế phẩm sinh học chứa vi khuẩn Bacillus subtilis giúp ức chế nấm Cercospora và Alternaria.

Bệnh đốm lá bí đao là một trong những bệnh phổ biến, gây hại nghiêm trọng nếu không được phát hiện và xử lý kịp thời. Để bảo vệ vườn bí luôn xanh khỏe, bà con nên chủ động phòng bệnh sớm, kết hợp giữa biện pháp canh tác, dinh dưỡng và phun thuốc hợp lý. Đặc biệt, sử dụng phân hữu cơ SATAKA định kỳ giúp cây phục hồi nhanh, lá dày khỏe, tăng sức đề kháng tự nhiên với nấm khuẩn.
LIÊN HỆ TƯ VẤN MIỄN PHÍ
TỔNG KHOZ – PHÂN BÓN CHÍNH HÃNG, GIÁ TỐT
Địa chỉ: 246 Nguyễn Kim Cương, Tân Thạnh Đông, Củ Chi, Thành phố Hồ Chí Minh
Hotline Kinh Doanh: 0856.77.66.99 – Hotline Kỹ Thuật: 085555.99.44
Trang web: Tổng KhoZ
Email: tongkhoz@gmail.com
Facebook: Tổng KhoZ

